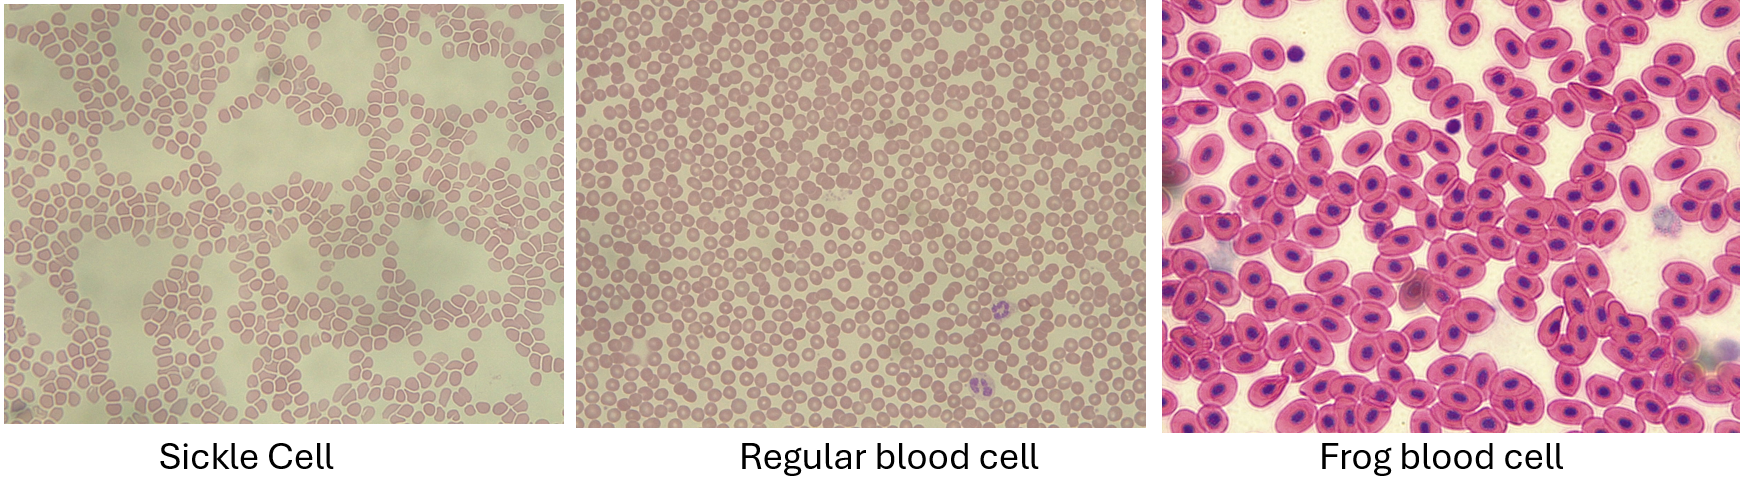
<p>Normal: round, plump looking<br>Sickle: concaved, get easily stuck on other things<br>Frog blood: nucleated</p>

BISC208 FINAL LAB UDEL- Mahuffy
1/55
Earn XP
Description and Tags
BISC208 Lab Final for Lynn Mahaffy; Spring Semester 2024
Name | Mastery | Learn | Test | Matching | Spaced | Call with Kai |
|---|
No analytics yet
Send a link to your students to track their progress
56 Terms
What is Evolution?
A change in the composition of the population
Does evolution occur in populations or individuals?
Populations
What is the main driving force behind evolution?
Natural selection
Do individuals mutate or evolve?
Mutate
What are the three requirements for evolution by natural selection?
1. Population must contain variation
2. The variation must be partly heritable
3. variants must survive to reproduce at higher rates than others
What is the role of mutation in evolution by natural selection?
Mistakes in the copying of DNA can lead to mutations which will add variation to a population.
True or false: Mutations can only be harmful.
False. Mutations can be harmful, helpful or have no effect.
What are examples of traits changing over time under given conditions?
1. How snail shell thickness changes over time when crabs can more easily eat thinner-shelled snails
2. How the average speed of a population of deer would change when predators can more easily catch slower deer
What gene/trait in clams was studied in our simulation and how did the two different versions of the gene affect the clams ability to survive a red tide algal bloom?
1. The clams are either affected by saxitoxin because they do not have the mutated gene
2. They are resistant to the saxitoxin because they have 1-2 mutated genes
What was Saxitoxin harmful to clams without the mutation?
Saxitoxin prevents transmission of nerve signals
What is the difference between genetic drift and natural selection? Give examples.
1. Genetic drift causes evolution by random chance due to sampling error
Ex: Fishing boat incident causing individuals not surviving to breed
2. Natural selection causes evolution on the basis of fitness
Ex: Red tides removed many of the sensitive clams
What is Paralytic Shellfish poisoning and what are its causes and effects?
1. Affects humans by eating clams that contain the saxitoxin but still have the resistant phenotype
2. Causes tingling sensation or difficulty breathing
What are the three basic components of an angiosperm?
1. Root system - Taproot and lateral roots (function: protection and nutrient absorption)
2. Shoot system - Stem (function: transportation)
3. Leaves - (function: photosynthesis)
List the functions of each of the following structures:
1. Stem
2. Petiole
3. Node
4. Leaves
5. Apical bud
6. lateral root
7. Tap root
8. Trichome
1. Stem: transport water and nutrients from roots to leaves
2. Petiole: twist the leaf to face the sun, allows leaves to stretch out farther from stem to use more sunlight
3. Node: attaches petiole to stem
4. Leaves: photosynthesis
5. Apical bud: allows for primary vertical growth
6. Lateral root: increase volume of soil reached, anchorage, water and nutrient uptake
7. Tap root: absorption and stability/anchorage
8. Trichome: limit water loss, protection from environmental stressors, or produce toxins against herbivores

What are the three tissue systems and what cells/structures make up each one?
Dermal: Trichomes and cuticle
Ground: Parenchyma, collenchyma and sclerenchyma
Vascular: Xylem and phloem

What is the function of the structures listed?
1. Cuticle
2. Trichomes
3. Stomata
4. Guard cells
5. Parenchyma
6. Collenchyma
7. Sclerenchyma
8. Xylem
9. Phloem
1. Cuticle: waxy cover that prevents water loss
2. Trichomes: hair like projections
3. Stomata: pores that open to allow carbon dioxide to enter and closes to prevent water loss
4. Guard cells: pores that open to allow carbon dioxide to enter and closes to prevent water loss (control opening and closing of stomata)
5. Parenchyma: contain chloroplast and responsible for photosynthesis
6. Collenchyma: cells that stretch allowing for the plant to be flexible
7. Sclerenchyma: provide for support (dead at maturity)
8. Xylem: transportation of water and nutrients from root to stem
9. Phloem: transportation of sugars from leaf to stem

What are the four basic organs of the flower?
Flower:
Sepal (protect flower bud), petals (attract pollinators)
Carpel (female gamete production)
Stamen (pollen/male gamete production)

What are the three basic components of the carpel and their function?
Carpel:
Stigma (sticky to trap pollen)
Style (stalk)
Ovary (female gamete production)

What are the two components of the stamen and their function?
Stamen:
Anther (pollen producer)
Filament (stalk that holds anther)

What is transpiration and why do plants transpire?
1. Transpiration is the water movement in plants; driven by a concentration gradient
2. Plants transpire to enhance nutrient intake in plants
How was the leaf impression with nail polish completed in lab?
We painted a thin layer of nail polish, let it dry and then used tape on the polish and gently pulled it off with the impression of the leaf.
How can measuring pressure in the tube attached to the cut stem provide information on the transpiration rate of a plant?
Volume of the air pocket increases and then pressure decreases.
The decrease in pressure is measured in kPa and this is used to calculate transpiration so the more pressure decreases, the more water is taken up by the plant
What data that was collected/ measured (pressure changes over time Kpa/sec) vs calculated (transpiration rate --> volume over time ul/min)
1. We directly collect the pressure changes in the air pocket (Kpa/sec)
2. We calculated how much water the plant draws up in the process of transpiration (ul/min)
What errors in the plant transpiration setup could lead to pressure values not decreasing?
1. Not having a snug enough fit in adaptor
2. Having air in the tube
3. 2 way valve is horizontal (allows flow when it is vertical)
Analyze the results of a transpiration experiment if a set of results is presented either in a graph or table format.
1. Negative values that are presented are the pressure decreasing so by making them positive values you are indicating the increase in water taken up by the plant.
2. Should form linear slopes
3. 1 kPa = 20 ul water taken up
what was the effect of coating the bottom surface of the leaf with oil on the transpiration rate, and explain why we see this effect?
1. Coating the bottom of the leaf decreased transpiration rate because it covers the stomata on the bottom of the leaf
What is a tissue?
A group of cells that are specialized for a specific function.
What is an organ?
A collection of tissues that are specialized for a specific function.
What is histology?
The study of tissues.
What are the characteristics of the 10 tissues observed in lab, their functions and where in the body they can be found?
Follow Next Ten Cards
1. Simple Cuboidal Epithelial
Characteristics: Single nuclei and cubed shape
Function: Secretion absorption, and protection
Location: Lines the glands and ducts

2. Stratified Squamous Epithelial
Chacteristics: Multiple layers of flat cells
Function: To protect
Location: Line the body and inside of the mouth

3.Simple Ciliated Columnar
Chacteristics: Single layer of column shaped cells
Function: Protection and increase surface area
Location: lines the nose

4. Smooth Muscle
Chacteristics: Central nuclei and no striations
Function: Involuntary movement
Location: Smooth muscle and digestive tract

5. Cardiac Muscle
Chacteristics: Branched patterns that striated
Function: Pumping blood and electrochemical signals
Location: Walls of the heart

6. Skeletal Muscle
Chacteristics: Long cells, multiple nuclei, and striations
Function: Generate force for voluntary movement
Location: Next to bone

7. Bone
Chacteristics: Osteons (tube of capillaries and nerves), osteocytes, and lacunae
Function: Protection and connection point
Location: bone

8.Blood
Chacteristics: Erythrocytes and Leukocytes
Function: Transportation of gasses and protection against infections
Location: blood

9.Neuron
Chacteristics: Branched dendrites, axon, and cell body
Function: Signal transportation and coordination
Location: Nervous tissue

10.Spinal Cord
Chacteristics: Branched dendrites, axon, and cell body
Function: Cell signaling between body and brain
Location: Spinal cord

Which side of the heart is oxygenated and which is deoxygenated? (RDLO)
Right side is deoxygenated and left side oxygenated.

How does blood travel through the heart and body?
Superior/inferior vena cava → right atrium → right ventricle → exits heart through pulmonary artery → lungs → back to heart through pulmonary veins → left atrium → left ventricle → aorta → body

What is the difference in structure between the right and left ventricles and why this is so?
The left ventricle is larger than the right because the left pumps blood to the whole body rather than just the lungs.

What is the purpose of the valves of the heart/ List the four valves in the heart.
Valves are there to prevent backflow
The bicuspid valve, the tricuspid valve, the pulmonary valve and the aortic valve

Describe the effect of various problems that can arise in the heart, based on your knowledge of the structures of the heart and their functions.
1. Blood clot blocking blood vessels leading to the heart: heart attack
2. Bicuspid valve not fully closing: backflow
3. Left ventricle thickens and stiffens: blood would not flow properly because heart can not pump as forcefully
4. Hole in the Septum wall between right and left atrium: blood from the right side flows into the left and vice versa. This could lead to deoxygenated blood traveling to the body and already oxygenated blood going to the lungs
Describe the structural differences between an artery and vein and why they have this difference?
Arteries: high pressure cause thicker walls
Veins: low pressure cause thinner walls
Describe the differences between and be able to identify from images normal human blood, sickle cell blood, and frog blood
Normal: round, plump looking
Sickle: concaved, get easily stuck on other things
Frog blood: nucleated
State what happens to heart rate and SpO2 levels at rest vs at exercise and explain how these changes demonstrate homeostasis.
Heart rate increases during exercise and SpO2 levels stay relatively stable. Ensure that oxygen is getting into the blood and Spo2 levels remain constant to maintain homeostasis.
Know the path of electrical signaling that starts in the motor neuron and ends in the contraction of the muscle by the shortening of sarcomeres (review Part A)
Action potential reaches end of motor neuron → ACh released into synaptic cleft → ACh binds to muscle cell receptors and causes depolarization of muscle cell (triggers action potential) → Action potential spreads through T tubules → Calcium channels open in sarcoplasmic reticulum → calcium ions released into muscle cell cytoplasm → calcium binds to troponin and tropomyosin and causes proteins to move allowing actin and myosin to interact → with ATP hydrolysis myosin filaments slide over actin (shorten) causing contraction

Be able to determine what is wrong in an abnormal EKG reading and what that means for the patient's heart
Before P-wave - Electrical signal originates in the sinoatrial node
P wave - signal travels over atria
Between P and Q - signal is delayed at the atrioventricular node
During QRS - signal spreads across ventricles, ventricles contract
T wave - ventricles relax

Explain the difference between exponential and logistic growth, in terms of what conditions produce each and how population growth rate changes with population size (relate to the graphs)
Exponential growth: the larger the population becomes the faster it will grow (sharp incline)
Comes from having no predators and an abundance of resources
2. Logistic growth: (gradual incline)

Explain what carrying capacity is and what determines the carrying capacity for a population.
Carrying capacity is the population size that can be supported by the resources the environment has.
Describe the pattern of growth in the moose population when there were no wolves. Was it purely exponential? Purely logistic? Why? What happened when 200 new moose were added?
The pattern of growth where there were no wolves were purely exponential because (until carrying capacity) because as long as there were resources the more moose there were the faster they could reproduce
2. When 200 moose were added, the population rose about the carrying capacity and there was a decrease back to carrying capacity
Describe the relationship between the moose and wolf population cycles
As moose population increased the wolf population did too and then would decrease (kind of happened in alternating cycles of who was higher)
Describe the effect of introducing wolves on the moose population, both in terms of moose population size and moose health (fat stores) - why do these changes occur?
Fat stores increased with the introduction of wolves because the ones with more fats stores were not killed as easily
The population size of the moose also decreased
Explain how a long growing season can sometimes lead to extinction?
Longer growing seasons allow the moose population to increase which then in turn increases the wolf population since both have a plethora of food. Eventually with the increase of predators, the prey population will decrease, and when there is not enough prey, the predator population will decrease as well causing extinction of both the moose and wolf populations.